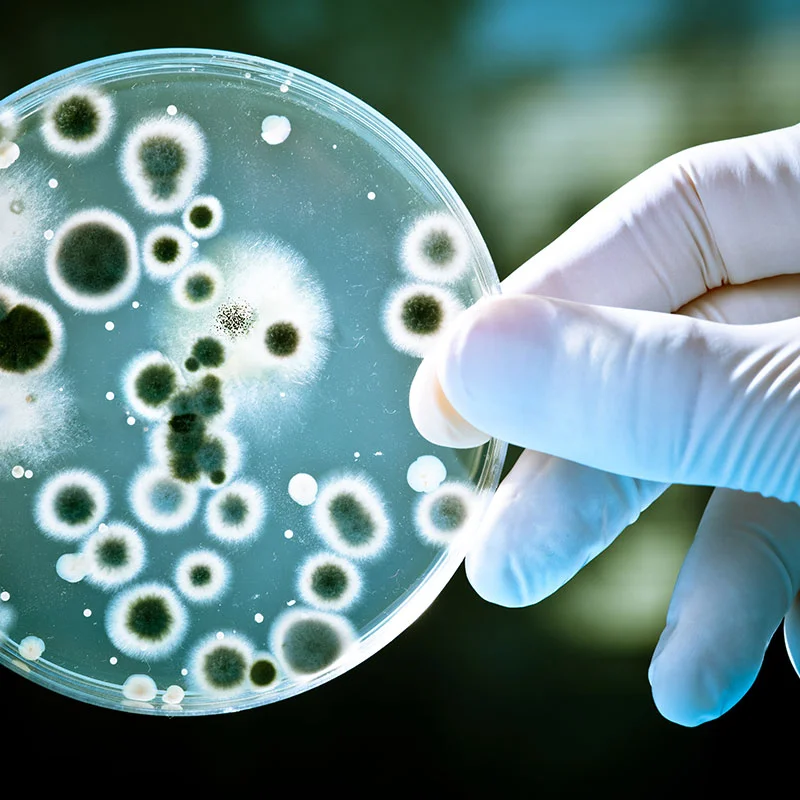

“Probiotics are the good bacteria themselves that fight off disease and boost your health. Alternatively, prebiotics act by feeding these beneficial probiotics, encouraging them to grow and flourish”
WHAT DO WE KNOW?
The most straightforward and rational way to affect our gut microbiota is through what we eat. A diverse diet can positively influence the landscape of our gut microbiome, leading to better health. Two key components in food that affect the gut microbiota are fibre and polyphenols, found in a wide variety of grains, fruits, vegetables, beans, and pulses. Probiotic bacteria found naturally in the environment and on our food can also have an effect, and are found in a variety of forms from fermented foods to supplements.
In the digestive process most of the nutrients from food are absorbed in the upper intestine. What’s left, for example fibre, then moves into the colon, home to the majority of the gut microbiome. The colon has three main roles; the propulsion and expulsion of its contents towards and out of the rectum and anus (as poo), absorbing water and electrolytes, and absorbing beneficial short-chain fatty acids produced by the gut microbiota (1). The gut microbiota produces these short-chain fatty acids by breaking down undigested nutrients through a process called fermentation, and also plays a role in the production of vitamin K and the B vitamins biotin and niacin.
THE IMPORTANCE OF FIBRE FOR A HEALTHY GUT
Fibre is a carbohydrate found in plant foods that the body cannot fully break down and digest and is commonly found in wholegrains, beans, pulses, fruits and vegetables. Certain types of fibre, called prebiotics, can help boost our numbers of ‘healthy’ bacteria including bifidobacterium and lactobacillus (2). The recommended daily intake of fibre is 30g per day (AOAC), however unfortunately most people in the UK don’t meet this amount. On average in the UK, women have only 17g of fibre a day and men only 20g a day (3). Getting enough fibre is important part of our diet and can have a multitude of benefits. A number of scientific studies have displayed that for every 7g of fibre you eat a day, particularly from wholegrains and cereal fibres, there is an 8% reduction in colorectal cancer risk, 9% reduction of cardiovascular disease risk, 7% reduction of stroke, and a 6% reduction in risk of type two diabetes (5).
PREBIOTICS
Not all fibre types act as food for our gut microbiota when they reach the colon, but those that do are called prebiotics (6). By feeding the healthy bacteria that are already resident in our gut, we can help them grow in numbers as well as encourage them to produce beneficial by-products. Prebiotic fibres such as fructo-oligosaccharides (FOS), galacto-oligosaccharides (GOS) and inulin are naturally found in some plants like bananas, chicory root, leeks, onions and Jerusalem artichokes.
Fruit and vegetables are not only great sources of fibre but also polyphenols, complex compounds with anti-oxidant properties. Polyphenols are responsible for the vibrant colours in fruits and vegetables but are also found in tea, coffee, red wine, beans and chocolate. Eating the rainbow is a common slogan we often hear, encouraging us to have a rich diversity of different types of polyphenols, fibre and other nutrients to optimise our nutrition. The body’s ability to digest and absorb polyphenols in the upper intestine is quite low, so about 90% enter the colon where they act like prebiotics by feeding the gut microbiota. It has been suggested that polyphenols and fibre work together, with fibre increasing the absorption of the polyphenols within the colon into the body, and polyphenols potentially positively influencing the fermentation of fibre by the gut microbiota (7).
Although to date there has been more research on probiotics, prebiotic research is expanding. Gut microbiota thrive off a diet rich in different types of fibre and polyphenols, so trying to include as many different types as part of a balanced diet can help support our microbiome for better health. A diet rich in different plant foods has been shown to increase beneficial short-chain fatty acid production with higher levels of prevotella and fibre-degrading firmicutes (8).
PROBIOTICS
Probiotics have been defined as live microorganisms that give a health benefit when taken in the right quantities (9). They tend to have more than one effect on the human body from inhibiting pathogens to supporting immune system responses (10, 11). Normally they do not permanently colonise in the gut, but rather are seen as welcome visitors that then pass through. Probiotics are most commonly consumed in yogurts and fermented products, but also dietary supplements and functional foods.
There is strong evidence, backed by numerous randomised controlled trials, that probiotics can have health benefits in certain areas, including treatment of antibiotic-induced diarrhoea, constipation and Irritable Bowel Syndrome (IBS) (12-14). However, unfortunately for some people a probiotic may have no impact whatsoever. Generally, it is recommended to try a probiotic for four weeks to see if it has any benefit for your symptoms.
Although there have been a limited number of scientific research on fermented foods, there is evidence that they may play a role in promoting health (15). Common fermented foods containing live bacteria include kimchi, sauerkraut, some cheeses and natural yogurt.
THE FUTURE OF DIET AND PROBIOTIC RESEARCH?
Research into the effects of diet on the microbiome is at an early stage but has promising therapeutic potential. In the future, specific strains of bacteria could be administered as treatment in the management of gut disorders and diseases like IBS and inflammatory bowel disease. More research is needed on the effect of nutrients, whole foods and dietary patterns on specific types of bacteria, as well as defining which bacteria are ‘healthy’, before diets can be fully personalised based on an individual’s gut microbiome.
REFERENCES
3. Dietary Fibre: British Nutrition Foundation; [updated 2018. Available from: https://www.nutrition.org.uk/nutritionscience/nutrients-food-and-ingredients/dietary-fibre.html.
5. (SACN) SACN. Carboydrates and Health. London: The Stationary Office; 2015.
GUTSY DIGEST
Two key components in food that affect the gut microbiota are fibre and polyphenols, found in a wide variety of grains, fruits, vegetables, beans, and pulses.
The gut microbiota produces short-chain fatty acids by breaking down undigested nutrients through a process called fermentation, and also plays a role in the production of vitamin K and the B vitamins biotin and niacin.
Certain types of fibre, called prebiotics, can help boost our numbers of ‘healthy’ bacteria including bifidobacterium and lactobacillus.
The recommended daily intake of fibre is 30g per day (AOAC), however unfortunately most people in the UK don’t meet this amount.
Probiotics have been defined as live microorganisms that give a health benefit when taken in the right quantities
There have been a limited number of scientific research on fermented foods, there is evidence that they may play a role in promoting health
More research is needed on the effect of nutrients, whole foods and dietary patterns on specific types of bacteria, as well as defining which bacteria are ‘healthy’, before diets can be fully personalised based on an individual’s gut microbiome.
For general nutrition information:
For easy to digest food facts:
To find out more about prebiotics and probiotics:
A clinical guide to different probiotics: